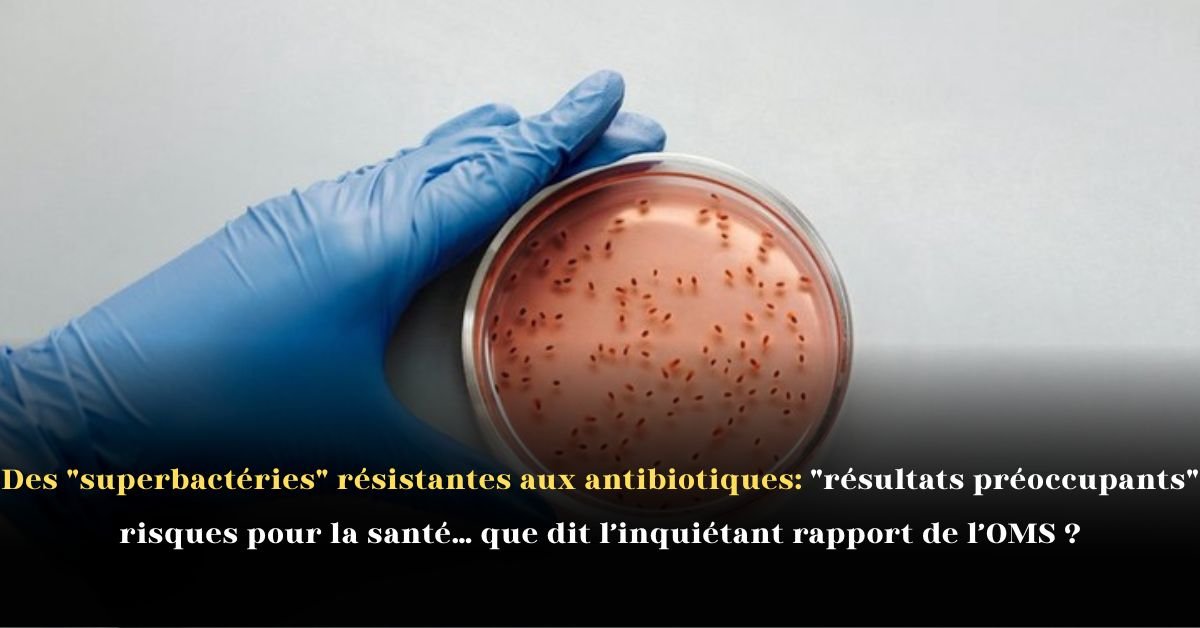
Des superbactéries résistantes aux antibiotiques: résultats préoccupants, risques pour la santé… que dit l’inquiétant rapport de l’OMS ?

Une Alerte Mondiale sur la Résistance aux Antibiotiques : La Crise des Superbactéries
L’Organisation mondiale de la santé (OMS) a publié un rapport 2025 inquiétant sur la montée rapide des superbactéries et de l’antibiorésistance. Cette menace silencieuse, souvent ignorée du grand public, est en train de transformer des infections autrefois bénignes en pathologies potentiellement mortelles.
Le directeur général de l’OMS, Tedros Adhanom Ghebreyesus, tire la sonnette d’alarme : les traitements antibactériens traditionnels sont de plus en plus inefficaces. Que vous soyez en France, au Québec ou ailleurs, ces bactéries résistantes aux antibiotiques menacent désormais la santé publique mondiale. Il est crucial de comprendre la gravité de cette évolution pour éviter une catastrophe sanitaire.
Rapport de l’OMS: des chiffres “préoccupants” sur la Résistance Antimicrobienne (RAM)
Les données collectées par l’OMS révèlent une augmentation spectaculaire et profondément préoccupante de la résistance antimicrobienne (RAM) sur la période 2018-2023. Ces chiffres soulignent l’urgence d’une intervention à l’échelle mondiale :
- Résistance Accrue : En 2023, une infection bactérienne sur six confirmée en laboratoire présentait déjà une résistance aux antibiotiques.
- Progression Alarmente : L’antibiorésistance mondiale a progressé de 40 % en seulement cinq ans. L’augmentation annuelle moyenne se situe entre 5 % et 15 %.
- Portée de l’Analyse : L’OMS a analysé la résistance sur 22 antibiotiques essentiels, couvrant des infections courantes telles que les infections urinaires, gastro-intestinales, et les septicémies.
Cette résistance bactérienne accélérée compromet l’efficacité des traitements, y compris ceux utilisés dans les hôpitaux pour soigner des infections graves en France, en Belgique ou en Suisse.
Les Conséquences Dévastatrices pour la Santé Mondiale
La progression des superbactéries résistantes dépasse largement la capacité de la médecine moderne à créer de nouveaux traitements. Ce fossé croissant est au cœur de la crise sanitaire mondiale que l’OMS tente de prévenir.
- Innovation Dépassée : Le manque de nouveaux tests diagnostiques rapides et de nouveaux antibiotiques efficaces est un frein majeur à la réponse. L’industrie médicale peine à suivre le rythme.
- Manque de Transparence : Yvan Hutin, responsable du département “Résistance aux antimicrobiens” à l’OMS, souligne que le manque de données et de transparence de nombreux pays (y compris en Afrique francophone) sur la RAM fait que le monde avance « à l’aveuglette » face à cette menace.
- Mise en Péril de la Médecine : Sans antibiotiques efficaces, des procédures médicales courantes comme la chimiothérapie, les greffes d’organes ou les césariennes redeviennent extrêmement risquées.
Projection Alarmante: 10 Millions de Morts par An d’ici 2050
L’aspect le plus inquiétant du rapport concerne les projections alarmantes pour l’avenir : Selon les estimations de l’OMS, si les tendances actuelles ne sont pas inversées, l’antibiorésistance pourrait devenir la première cause de mortalité mondiale d’ici 2050, causant jusqu’à 10 millions de décès par an C’est un scénario où les infections les plus simples, comme une angine ou une coupure, pourraient redevenir mortelles, ramenant l’humanité à l’ère pré-antibiotique.

Conclusion
Un Appel Urgent à l’Action Mondiale Contre la RAM
L’OMS met en garde : l’augmentation rapide de la résistance bactérienne aux antibiotiques pose un défi majeur pour la médecine moderne. Les traitements efficaces se réduisent, tandis que les options thérapeutiques nouvelles se font rares.
Pour éviter une crise sanitaire potentiellement catastrophique, l’OMS appelle à une mobilisation planétaire immédiate et concertée. Il est vital:
- D’Investir dans la Recherche de nouveaux antibiotiques et de tests rapides.
- De Mettre en Place des Programmes de Surveillance transparents (notamment dans les hôpitaux français et québécois).
- D’Encourager une Utilisation Responsable des antibiotiques en médecine et en agriculture (« One Health »).
L’humanité est à un tournant critique. Les superbactéries ne sont plus une menace du futur — elles sont déjà là, et leur progression rapide nécessite une action urgente.
Disclaimer
Les informations présentées dans cet article sont basées sur les données et les conclusions officielles de l’Organisation Mondiale de la Santé (OMS) publiées dans son rapport sur la résistance antimicrobienne. Il s’agit d’un article informatif et éducatif. Les lecteurs sont priés de consulter les sources officielles de l’OMS et les autorités sanitaires nationales pour les mises à jour et les recommandations spécifiques à leur région.